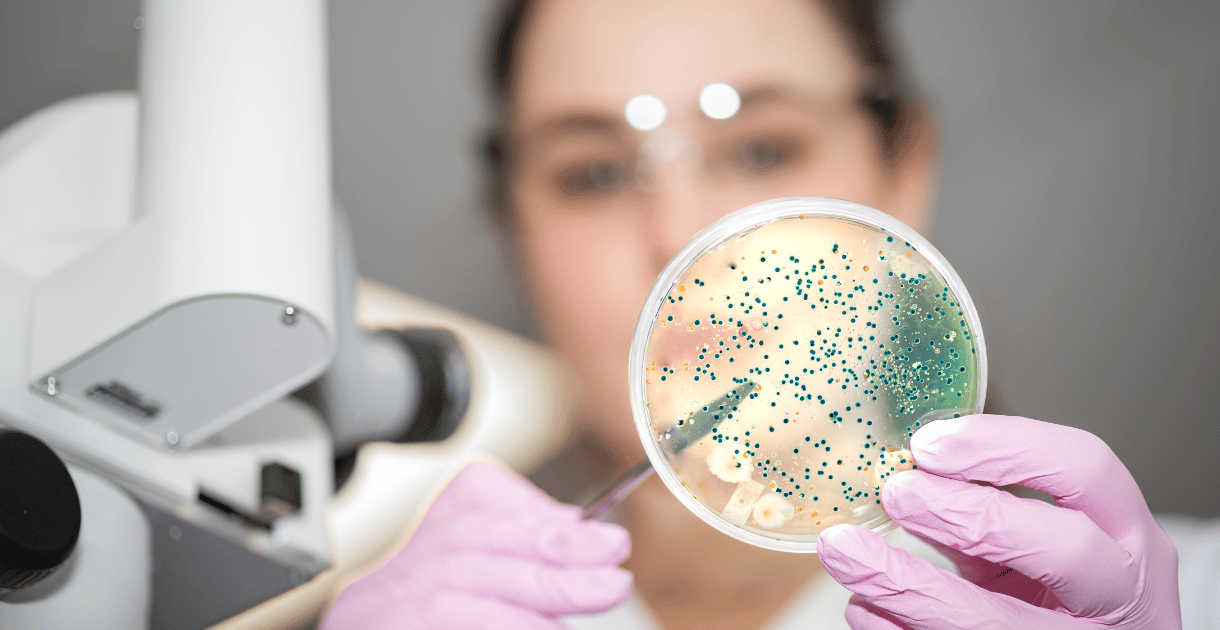
Scientist examining a petri dish, highlighting the use of bacterial filters in laboratory research.

The significance of respirators on job sites
The critical role of respirators in workplaces characterized by dust, smoke, or vapors cannot be emphasized enough. Let’s delve into an exploration of the

The critical role of respirators in workplaces characterized by dust, smoke, or vapors cannot be emphasized enough. Let’s delve into an exploration of the

A respirator is an indispensable tool for tasks involving airborne particles, hazardous vapors from chemicals, or work in dusty environments. To ensure your safety

Workers across diverse industries are mandated to wear respirators, crucial safeguards against inadequate oxygen environments, harmful dusts, fogs, smokes, mists, gases, vapors, and sprays.

Ensuring precise and reliable results in laboratory and research applications begins with choosing the right syringe filter. Here’s a comprehensive guide outlining 12 crucial steps

Syringe filters stand as indispensable tools in diverse laboratory and research applications, ensuring precise and dependable filtration. The market offers a variety of syringe filter

A syringe filter stands out as a crucial and versatile tool widely applied across different laboratory and industrial settings. Its primary job is to clear
In the dynamic landscape of healthcare, the spotlight is increasingly focused on infection prevention strategies, with bacterial filters emerging as indispensable tools in this ongoing

In the ever-evolving landscape of healthcare, the need for stringent infection control measures has never been more critical. Hospitals, once regarded as sanctuaries of healing,

The continuous evolution of medical technology has paved the way for innovative solutions to enhance patient care and safety. In the domain of infection prevention,

In the realm of healthcare, maintaining a sterile and bacteria-free environment is crucial for patient safety and well-being. One key component in achieving this goal
了解 EG TECH System Sdn Bhd 如何利用我们先进的铝模板解决方案支持您的下一个建筑项目。立即联系我们,了解更多产品和服务信息,或向我们的专家团队咨询。
EG Tech System Sdn Bhd (1511216-P)
© 2025 EG Tech System。保留所有权利。
我们随时恭候您的光临!如果您有任何问题,请发送邮件给我们!